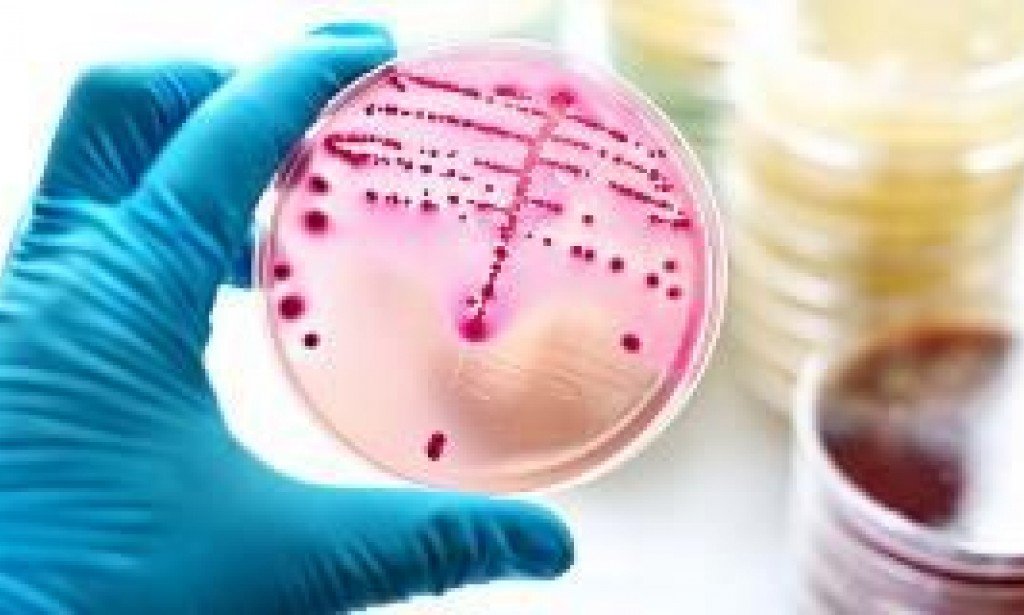
الميكروب السبحى

الميكروب السبحى
-
دائمًا ما نسمع أن البكتيريا تنتشر من حولنا وتسبب لنا العديد من الأمراض المختلفة، لذلك عندما يصاب الجسم بعدوى بكتيريا تتمكن بعض أنواع البكتيريا من التسلل إلى جسم الإنسان والحيوان والتسبب في إمراضه، بينما البعض الآخر مهم في تصنيع بعض المنتجات المخمرة، ومن عظمة خلق الله ان الجسم يكون أجسام مضادة اتجاه، حيث تقوم الأجسام المضادة بمقاومة الميكروب وحث الجهاز المناعي على مقاومته.

-
والبكتيريا ما هي إلا كائنات حية وحيدة الخلية توجد في كل مكان، في الهواء والتربة والماء والنباتات والحيوانات، كما توجد البكتيريا النافعة في الأمعاء، حيث أنها تقضي على الميكروبات التي تسبب الأمراض.
-
عادة من الصعب علاج هذه الأمراض بالمضادات الحيوية، لكن في بعض الحالات، تكون البكتيريا مقاومة للمضادات الحيوية، وتعجز هذه الأدوية عن قتلها ومن أنواع تلك البكتيريا الميكروب السبحي.
-
ما هو الميكروب السبحى
-
هو نوع من أنواع البكتيريا، حيث يوجد هناك عدة أنواع، اثنان منهم يسببان معظم الالتهابات العقدية لدى الناس: فئة( أ) وفئة(ب)حيث ينتقل عن طريق السعال والعطس.
-
تسبب بكتيريا فئة (أ)ألفا:
التهاب الحلق ويسمى ايضا بإلتهاب الحلق الأحمر، قد تنتفخ اللوزتان وتظهر عليها بقع بيضاء, اما الحمى القرمزية - مرض يتبع التهاب الحلق و يسبب طفح جلدي أحمر على الجسم والحمى الروماتيزمية وحمى النفاس ومتلازمة الصدمة السمية العقدية والتهاب الحلق والتهاب اللوزتين والتهابات الجهاز التنفسي العلوي الأخرى وهى عدوى سريعة الانتشار تصيب الجلد والأنسجة الكامنة التي تسببها S, المقيحة، باسم "مرض أكل اللحم وهذه المجموعة شائعة جدا.
-
أما فئة(ب)بيتا:
المكورات الرئوية فهي عدوى جلدية تسمى بمتلازمة الصدمة السامة وهوالتهاب نسيج خلوي، يمكن ان يسبب التهاب في المثانة والرحم عند النساء الحوامل، والأطفال حديثي الولادة وقد تؤدي عدوى البكتيريا إلى تعفن الدم (تسمم الدم).
يمكن أن تسبب البكتيريا العقدية من المجموعة ب التهابات الدم والالتهاب الرئوي والتهاب السحايا عند الأطفال حديثي الولادة وهو(التهاب الأغشية التي تغطي الدماغ والحبل الشوكي).
ومن الممكن إن المضادات الحيوية الوريدية (IV) أثناء المخاض يمكن أن تنقذ حياة طفلك، واجراء وقائى يتم اختبار معظم النساء الحوامل كجزء من الفحص الروتيني قبل الولادة، يُجرى الاختبار عادةً في الأسبوع السادس والثلاثين أو السابع والثلاثين من الحمل، و يمكن استخدامه أيضًا لاختبار الأطفال الذين تظهر عليهم علامات العدوى.
عندما تقوم الأم بعمل تحليلASOT لجنينها وعند وجود ارتفاع ف نسبته فيتم إتخاذ دواء بنيسلين طويل المفعول للطفل لفترات طويلة، وايضا يمكن أن يصاب البالغون أيضًا بالعدوى العقدية من المجموعة ب، خاصةً إذا كانوا يبلغون من العمر 65 عامًا أو أكبر أو يعانون بالفعل من مشاكل صحية، وحيث ان البكتيريا Strep Bتسبب التهابات المسالك البولية والتهابات الدم والتهابات الجلد والالتهاب الرئوي عند البالغين.
لوحظ ان العديد من السلالات تعيش بشكل طبيعي في البشر ولا تسبب أي أعراض.
أعراض عدوى الميكروب السبحى
1. صعوبة في التنفس واحتقان في الحلق.
2. نقص النشاط والحركة.
3. ارتفاع في درجة الحرارة.
4. فقدان الشهية.
5. الحمي.
6. مشكلة في الرضاعة.
7. صداع.
ويمكن استشارة الدكتور عند ظهور تلك الأعراض حيث انه يقوم بفحص الحلق والتأكد من وجود إلتهاب بكتيري(ميكروب السبحى) عن طريق تورم فى الغدد اللمفاوية للكباروعمل مسحة الجزء الخلفي من الحلق الخاص بالمريض وجمع عينة، ومن ثم يتم إرسال العينة إلى المختبر للبحث عن علامات البكتيريا.
-
علاج الميكروب السبحى
-
يتم عن طريق المضادات الحيوية ويعتبر البنسلين والأموكسيسيلين هي الأدوية الأكثر شيوعًا التي تُعطى لعلاج عدوى بكتيريا الحلق، اما اذا كان المريض يعانى من حساسية للبنسلين أو الأموكسيسيلين، يقوم الدكتور بوصف أزيثروميسين كمضاد حيوي أخر.
-
حيث أن الإفراط في استخدام المضادات الحيوية يسبب خلق سلالات من البكتيريا المقاومة لهذه المضادات الحيوية، والقضاء على البكتيريا النافعة في الجسم، وبالتالي يسمح للجراثيم السامة في التكاثر بالجسم بسهولة.
-
لا بدّ من معرفة الفرق بين كل من التهاب الحلق البكتيري والفيروسي، وذلك لما له من أهمية في عملية الوقاية والعلاج من الإصابة من هذا النوع من الالتهابات.
-
سوف نعرض لك أعراض التهاب الحلق البكتيري لكي تكن لك القدرة على التفرقة بينهما وهذه بعض الأعراض التي يشعر بها المريض عند الإصابة ب
1. إلتهاب الحلق البكتيري:
ألم شديد في الحلق.
كحة مع صوت شهيق يعقبها.
التهابات مصحوبة ببيقع بيضاء على الحلق.
المخاط الأصفر او الأخضر.
ارتفاع شديد في درجة حرارة الجسم.
2. التهاب الحلق الفيروسي
من المعروف أن الفيروسات أصغر من البكتيريا، وتقوم بربط نفسها بالخلايا، وتستمر في الحياة لفترة أطول، كما أن أغلب أنواع الفيروسات تسبب الأمراض، وتعد نزلات البرد (Common cold) والتهاب الحلق من أبرز الأمراض الشائعة التي تسببها الفيروسات، إلى جانب بعض الأمراض الجلدية مثل؛ الهربس (Herps) وجدري الماء.
تتطلب الالتهابات الفيروسية الحصول على لقاح للوقاية منها ولتخفيف أعراضها، وفي حالة الإصابة بها، يكون العلاج من خلال أدوية مضادة للفيروسات، والحصول على الراحة لمساعدة الجهاز المناعي في مقاومتها والتغلب عليها.
عادةً ما ينتهي التهاب الحلق الفيروسي بمفرده مع مرور الوقت، ولكنه يسبب مجموعة من الأعراض مثل؛ الشعور بالألم والحمى والسعال.
سواء كان الإلتهاب بيكتيري او فيروسي يمكن القيام ببعض الإجراءات لتخفيف الالتهاب، وهي:
الغرغرة بالماء والملح، تناول الكثير من السوائل طوال اليوم مثل: اليانسون، البابونج، عمل خليط من الماء والعسل بإضافة معلقة عسل الى كوب ماء دافئئ
ومحاولة التخلص من انسداد الأنف، والحصول على قسط من الراحة.
يجب عليك تسجيل الدخول لتستطيع كتابة تعليق